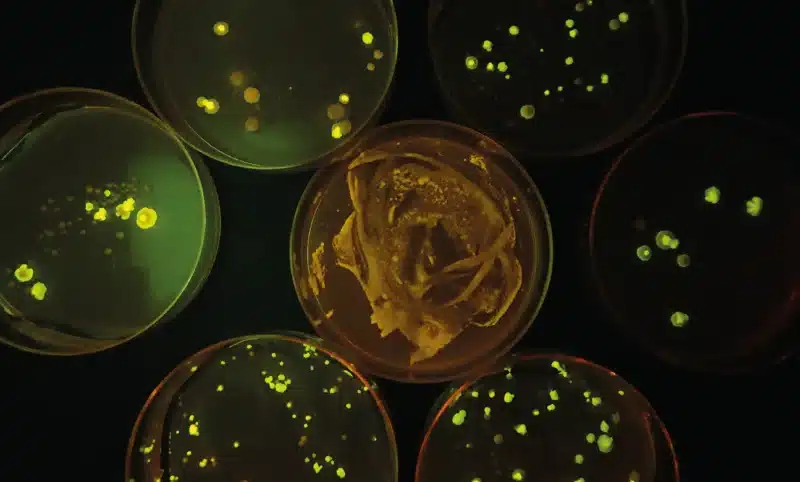
Syv petriskåle med PCR GFP-transformeret gær lyser grønt og gult på agar, set ovenfra i dæmpet belysning.

Højdepunkter
PCR GFP-transformeret gær
1.499,00 kr. (1.873,75 kr. m/moms)
Formålet med det praktiske arbejde: Bekræft tilstedeværelsen af GFP-genet, der er ansvarlig for fluorescensen af en transformeret gær ved PCR-amplifikation.
Den studerende har 2 stammer af S. cerevisiae:
– 1 utransformeret vild stamme (kontrol)
– 1 stamme transformeret med GFP
Den komplette manipulation udføres i 3 trin: ekstraktion/oprensning af prøven, amplifikation ved PCR og elektroforese på agarosegel.
Den studerende kan også teste de stammer, der er opnået gennem Yeast Transgenesis Lab ref. 117115. Protokollen og primerne er kompatible.
Bestil 2 uger før den ønskede modtagelsesdato.
Angiv den ønskede modtagelsesdato inden bestilling.
Leveringer sker udelukkende tirsdage og onsdage før kl. 13.00.
Varighed af det praktiske arbejde: 2 sessioner á 60 minutter
Format for 20 studerende
Opbevaring: 12 måneder ved -20 °C
Tilgængelig på restordre|Forventet leveringstid (dage): 7